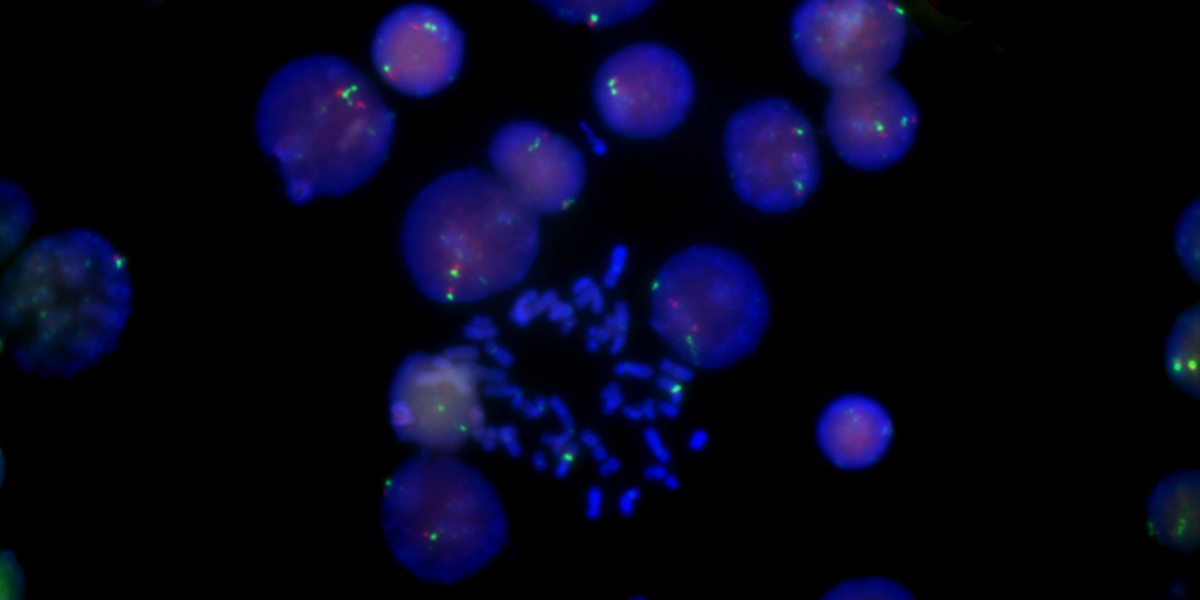

微信掃描二維碼,點擊右上角 ··· 按鈕
轉發給朋友或分享到朋友圈

MFISH熒光原位雜交分析系統
聯系客服MFISH熒光原位雜交分析系統是專為FISH熒光原位雜交成像捕捉和處理開發的軟件,可自動提取和增強FISH標記的靶DNA分子或RNA分子信號,對目標DNA區域或RNA分子在染色體或其他細胞器中進行定位,或確定目標細胞或細胞器的形態和分布。
快速曝光,一鍵成像
成像自動優化
可滿足不同顏色探針

留言
微信掃描二維碼,點擊右上角 ··· 按鈕
轉發給朋友或分享到朋友圈